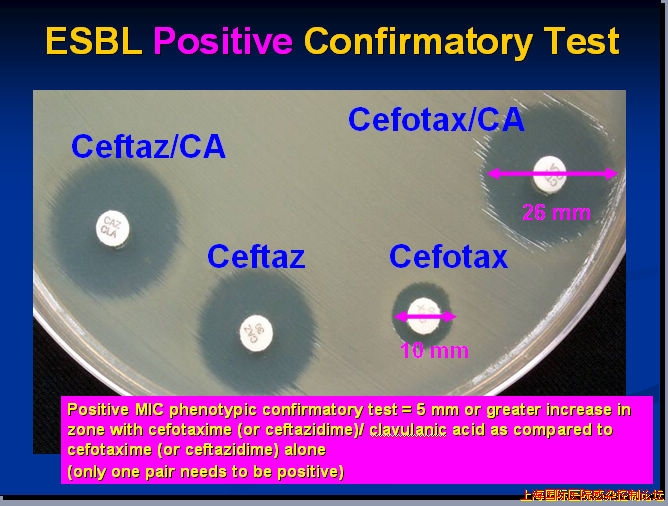

本帖最后由 sunlight 于 2011-2-20 18:14 编辑
回复 22# 斯佳丽
您医院微生物学实验室对于产ESBL株的初筛试验方法是错误的。当时,看您帖子的时候就感觉很纳闷,肠杆菌科的药敏怎么会选头孢哌酮?由于不知道您院实验室是如何筛选ESBLs ,所以只就您提出的问题进行了答复。CLSI(第20版)规定了对产ESBL的初筛试验和确证试验的试验方法,判读标准以及如何报告等内容。 产ESBLs的初筛试验(纸片扩散法):
肺炎克雷伯菌、产酸克雷伯菌 和 大肠埃希菌 : 头孢泊肟 ≤ 17 mm 头孢他啶 ≤ 22 mm 氨曲南 ≤ 27 mm 头孢噻肟 ≤ 27 mm 头孢曲松 ≤ 25 mm 奇异变形杆菌 : 头孢泊肟 ≤ 22 mm 头孢他啶 ≤ 22 mm 头孢噻肟 ≤ 27 mm 以上抑菌环直径可指示产ESBLs 产ESBLs的确证试验(纸片扩散法): 头孢他啶 30 u g 头孢他啶 / 克拉维酸 30/10 ug 以及 头孢噻肟 30 ug 头孢噻肟 / 克拉维酸 30/10 ug (确证试验需要同时使用头孢噻肟和头孢他啶 , 单独和联合含有克拉维酸的复合制剂)
对两组中任何一个药物 , 在加克拉维酸后,抑菌圈与不加克拉维酸的相比,增加值 ≥ 5mm 时,判定为产ESBL (如,头孢他啶的抑菌圈直径= 16mm ;头孢他啶 / 克拉维酸的抑菌圈=21mm) 报告: 对于所有经确证为产 ESBL 的菌株 : 如果实验室还没有执行新的头孢菌素和氨曲南的解释标准 , 实验结果应该报告为对所有青霉素类、头孢菌素类和氨曲南耐药。 如果实验室已经执行了新的头孢菌素和氨曲南的解释标准 , 实验结果的解释不必作修改。
|  /1
/1 